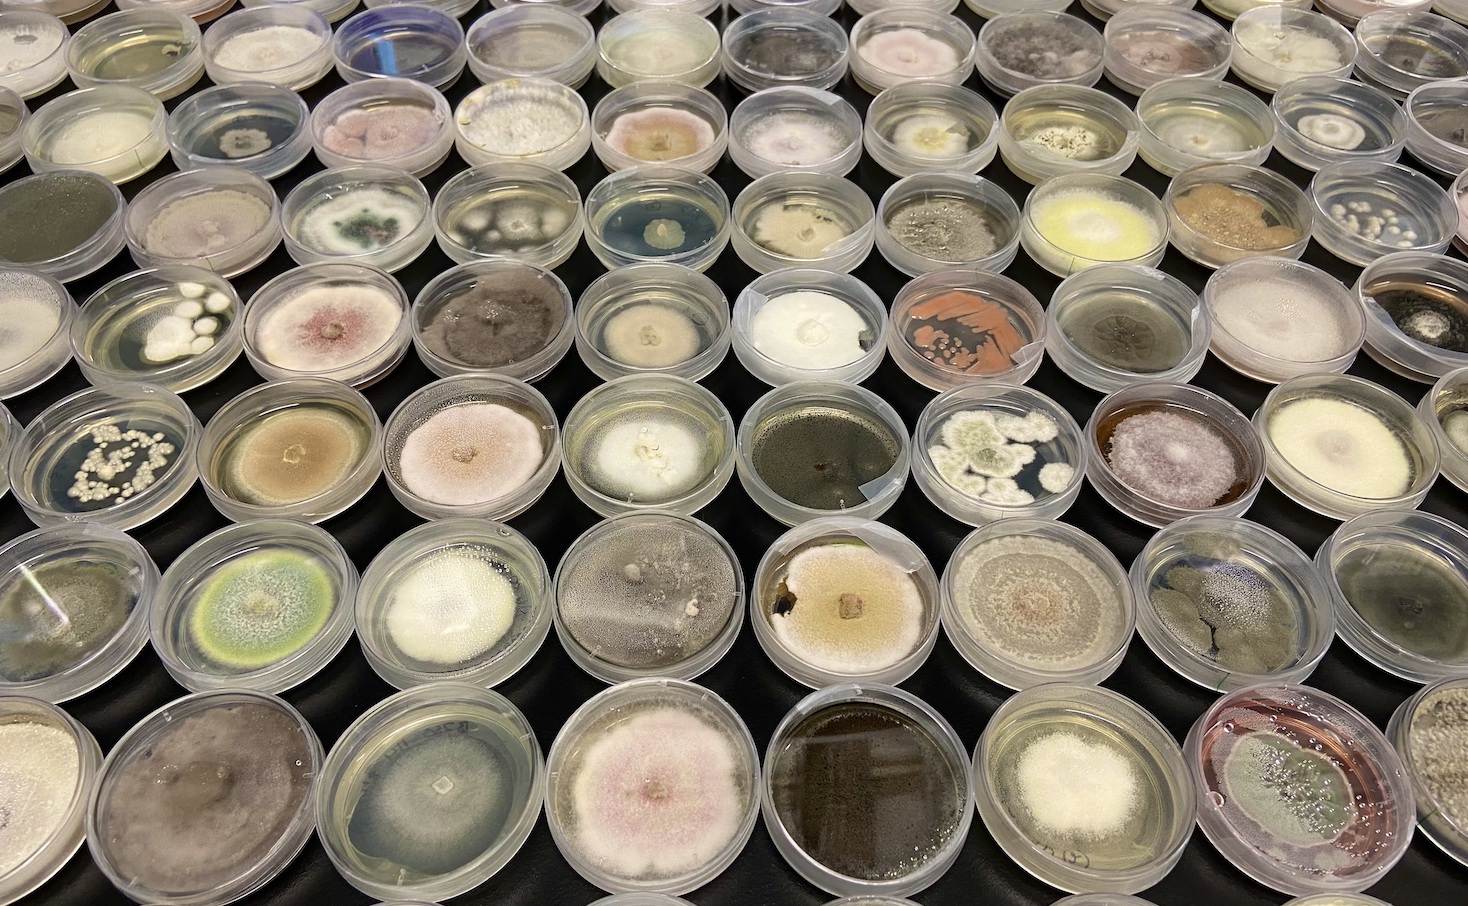
why-the-market-for-mopping-up-‘forever’-chemicals-is-exploding

Why the market for mopping up ‘forever’ chemicals is exploding
Synthetic biology startup Allonnia just raised $30 million more for tech to remediate PFAS.
Synthetic biology startup Allonnia just raised $30 million more for tech to remediate PFAS.





